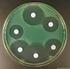
Staphylococcus aureus Concetta Scalfaro Istituto Superiore di Sanità

Genere Staphylococcus
|
|
|
- Bartolomeo Carella
- 9 anni fa
- Просмотров:
Транскрипт
1 UNIVERSITA' degli STUDI di PERUGIA Facoltà di FARMACIA Corso di Laurea in FARMACIA Genere Staphylococcus Fisiologia e struttura Patogenesi e immunità Epidemiologia Sindromi cliniche Diagnosi Trattamento - Prevenzione - Controllo
2 cocchi Gram +: 21 generi che colonizzano l uomo i generi catalasi + sono: Staphylococcus Micrococcus Alloiococcus Stomatococcus i generi catalasi - sono: Streptococcus Enterococcus
3 Disposizione spaziale delle Coccaceae Staphylococcus (stafulh = grappolo)
4 Genere Staphylococcus cocchi Gram+ diametro di micron immobili asporigeni capsulati anaerobi facoltativi catalasi + T di crescita: C alofili (NaCl 10%) Specie patogene per l uomo: S. aureus S. epidermidis S. haemolyticus S. lugdunensis S. saprophyticus
5 Staphylococcus aureus FISIOLOGIA E STRUTTURA STRUTTURA DELLA PARETE Capsula e slime layer Peptidoglicano Acido teicoico (Polisaccaride A) Citoplasma Proteina A Fattore di coagulazione Membrana citoplasmatica
6 Staphylococcus aureus Effetti sull ospite (locali e sistemici) Le IgG si legano alla proteina A Proteina A Capsula Tossine Antigeni e Superantigeni - attività antifagocitaria - danneggiamento della membrana cellulare - induzione del rilascio di citochine ADESIONE Coagulazione, Danneggiamento dei tessuti, etc
7 CAPSULA O SLIME: è di natura polisaccaridica impedisce la fagocitosi e la chemiotassi nei confronti dei PMN facilita l adesione a cateteri, protesi valvolari Staphylococcus aureus FISIOLOGIA E STRUTTURA PEPTIDOGLICANO legame crociato: pentaglicina da L-lys a D-ala
8 Staphylococcus FISIOLOGIA E STRUTTURA ACIDI TEICOICI: polimeri specie-specifici legati covalentemente al peptidoglicano ACIDI LIPOTEICOICI: legati con legame lipofilo alla membrana citoplasmatica Mediano l attacco degli stafilococchi alla FIBRONECTINA S. aureus: acido ribitol-teicoico (polisaccaride A) S. epidermidis: acido glicerol-teicoico (polisaccaride B)
9 PROTEINA A: copre tutta la superficie del batterio. possiede una spiccata affinità di legame per il recettore Fc di IgG1, IgG2 e IgG4, bloccandone la funzione. ha funzione antigenica attiva il Complemento Staphylococcus FISIOLOGIA E STRUTTURA Non è presente sugli stafilococchi che non producono l enzima coagulasi (coagulasi-negativi)
10 L adesione batterica è mediata da una famiglia di proteine ADESINE indicate con l acronimo MSCRAAM: Microbial Surface Components Recognizing Adhesive Matrix Molecule capaci di interagire specificamente con proteine della matrice extracellulare (fibronectina, collagene, laminina e fibrinogeno).
11 Staphylococcus aureus - FATTORI DI VIRULENZA COMPONENTI STRUTTURALI capsula peptidoglicano proteina A acido teicoico ENZIMI coagulasi catalasi ialuronidasi fibrinolisina lipasi nucleasi penicillinasi TOSSINE citotossine (a, b, g, d, Leucocidina P-V) tossine esfoliative (ETA, ETB) enterotossine (A-E, G-I) TSST-1
12 Staphylococcus aureus - FATTORI DI VIRULENZA ENZIMI Coagulasi reagendo con un fattore presente nel plasma e trasforma il fibrinogeno in fibrina li aggrega e protegge il batterio dalla fagocitosi
13 Principali specie responsabili di patologie infettive Coagulasi + Staphylococcus aureus Staphylococcus epidermidis Coagulasi detti anche CoNS Staphylococcus haemolyticus Staphylococcus hominis Staphylococcus lugdunensis Staphylococcus saprophyticus Staphylococcus warneri
14 Staphylococcus ENZIMI Catalasi Converte il perossido di idrogeno in H 2 O ed ossigeno Nucleasi Staphylococcus aureus, DNAsi + Staphylococcus saprophyticus, DNAsi -
15 Staphylococcus aureus TOSSINE Fattori citolitici: 4 tossine alfa, beta, gamma, delta leucocidina di Panton-Valentine Lisano i leucociti (soprattutto PMN) con rilascio di enzimi lisosomiali che provocano danno ai tessuti circostanti.
16 Staphylococcus aureus TOSSINE Tossina gamma e Leucocidina di Panton-Valentine LukF sono tossine bicomponente (componente F e componente S) agiscono lisando PMN e macrofagi producono dei pori, aumentano la permeabilità delle membrane cellulari causando instabilità osmotica LukS
17 Sindromi cliniche da Staphylococcus aureus Sindromi mediate da tossine Sindrome della cute ustionata Sindrome dello shock tossico Intossicazione alimentare Infezioni cutanee Infezioni profonde
18 Responsabile: tossina esfoliativa La tossina evoca la produzione di anticorpi neutralizzanti proteggenti che portano alla risoluzione del processo tossico. La patologia colpisce i bambini di 1-3 anni
19 Sindrome Stafilococcica della Cute Scottata (SSSS) o Malattia di Ritter Clinica: dermatite esfoliativa, colpisce i bambini di circa 1 anno caratterizzata da: eritema periorale Staphylococcus aureus vescicole cutanee con fluido chiaro con o senza microrganismi e leucociti Il recupero si ha dopo 7-10 giorni quando compaiono gli anticorpi.
20 Sindrome da Shock tossico Si deve all uso di tamponi iperassorbenti, dove si moltiplicano i batteri che liberano la tossina. Clinica: Ipotensione, febbre, rash sul palmo delle mani e la pianta del piede, seguito da desquamazione. Può interessare più organi (tratto GI, renale, epatico, ematico, SNC) Staphylococcus aureus
21 Intossicazioni alimentari Responsabili le 8 enterotossine (A-E, G-I), più 3 sottospecie della enterotossina C Ingestione di alimenti contenenti le enterotossine (patate salate, gelati, polli, carni, hamburger, creme) Periodo d incubazione: 5-6 ore Le enterotossine sono buoni induttori di IL-1 Stimolano la peristalsi intestinale, hanno un effetto sul SNC e sono responsabili del vomito. Manifestazioni cliniche: nausea, vomito, diarrea, dolori addominali, sudorazione, cefalea.
22 Follicolite Staphylococcus aureus Infezioni cutanee (1) Infezioni cutanee Infiammazione della porzione superficiale del follicolo pilifero (sicosi della barba) Foruncolo Infezione acuta e spesso necrotica che si sviluppa nella porzione profonda del follicolo pilifero. Si presenta come una piccola lesione dolente che tende alla suppurazione Favo Aggregato di foruncoli, con Intensa reazione infiammatoria ed interessamento del tessuto connettivo circostante
23 Impetigine Piodermite superficiale Staphylococcus aureus Infezioni cutanee (2) Colpisce soprattutto i bambini Contagiosa Infezioni cutanee Chiazzette eritematose lesioni pustolo-bollose bianco-giallastre caduta del tetto della pustola crosta caduta della crosta gemizio di essudato contagioso Orzaiolo: quando l infezione si verifica alla base delle palpebre. Sicosi della barba: l infezione dei follicoli piliferi nella zona della barba.
24 Infezioni Staphylococcus cutanee aureus Infezioni cutanee (3) Ascesso stafilococcico
25 Staphylococcus Infezioni profonde aureus Batteriemia a volte il sito d'infezione primaria è noto (polmone, tratto urinario, tratto gastrointestinale), a volte no (cute??) spesso segue disseminazione a siti distali: cuore (endocardite) ossa (osteomielite) articolazioni (artrite) Endocardite acuta: mortalità del 50%
26 Staphylococcus Infezioni ospedaliere aureus Infezioni ospedaliere: contaminazione di cateteri intravascolari
27 Staphylococcus aureus Infezioni ospedaliere Infezioni di ferite: in seguito ad interventi chirurgici (surgical site infection) Artrite settica: dolore all articolazione ed eritema. Per aspirazione si può prelevare materiale purulento.
28 Diagnosi delle infezioni da Staphylococcus aureus materiale ascessuale (agoaspirato) materiale bioptico sangue campioni respiratori tamponi altri Esame microscopico: cocchi Gram+ a grappolo Esame colturale: semina in terreno MSA
29 Identificazione Colonie lisce, convesse, a margini netti, +/- lucenti Colore delle colonie: giallo oro/bianco grigiastro Emolisi in Agar Sangue: presente/assente Gram: Cocchi gram positivi Catalasi: positiva Coagulasi: positiva/negativa
30 Diagnosi delle infezioni da Staphylococcus aureus Esame microscopico diretto cocchi Gram positivi ad ammassi emocoltura aspirato da ascesso
31 Isolamento colturale semina in terreni solidi e/o liquidi Terreni di base Terreni selettivi/differenziali AGAR SANGUE MANNITOL SALT AGR PARTICOLARITA Small colony variants: piccole colonie di S. aureus crescono dopo 48 h di incubazione non sono b-emolitiche di solito sono resistenti
32 Diagnosi delle infezioni da Staphylococcus aureus coagulasi Coagulasi legata: solo S. aureus è positivo Coagulasi libera: anche altre specie positive (ad es. S. lugdunesnis)
33 Diagnosi delle infezioni da Staphylococcus aureus Esame sierologico: ricerca degli Ab anti acidi teicoici
34 S. aureus: evoluzione della antibiotico-resistenza (1) S. aureus Penicillina [anni 50] S. aureus penicillino-resistente Meticillina [anni 80] S. aureus meticillino-resistente (MRSA) Vancomicina [anni 90] [anni 90] Enterococcus sp vancomicino-resistente (VRE) S. aureus intermedio-vancomicina [1997] (VISA)
35 Meccanismi di resistenza Resistenza a: Meccanismo alla base: Gene Penicillina Meticillina Beta-lattamasi PBP2a Plasmidico meca Vancomicina low level resistance Vancomicina high level resistance Intrappolamento nel cell wall Peptidoglicano modificato che non lega la V. vana
36 Staphylococcus aureus controllo e terapia La Vancomicina è il farmaco di elezione nei MRSA. Nuova classe di antibiotici: Oxazolidinoni LINEZOLID (in Italia Zyvoxyd ) Lavarsi le mani, pulire le ferite, disinfettare la cute. Uso di saponi germicidi, iodio, esaclorofene Controllo dei portatorinasofaringe Chemioprofilassi : Vancomicina+Rifampicina
37 tigeciclina (Tygacil, Wyeth Pharmaceuticals) nuova classe di antibiotici denominati glicilcicline (tetracicline modificate) Tygacil è attivo in vitro contro molti batteri resistenti a più farmaci come lo Stafilococco aureo resistente alla meticillina (MRSA) e l'enterococco resistente alla vancomicina (VRE) Inibisce la sintesi proteica agendo sul ribosoma 30S
Battericon significato clinico nell uomo
 Battericon significato clinico nell uomo Cocchi Gram+: Stafilococchi, Streptococchi, Pneumococchi Bacilli Gram+: Corinebatteri Bacilli Gram+ Aerobi (Bacilli) Bacilli Gram+ Anaerobi (Clostridi) Cocchi Gram-:
Battericon significato clinico nell uomo Cocchi Gram+: Stafilococchi, Streptococchi, Pneumococchi Bacilli Gram+: Corinebatteri Bacilli Gram+ Aerobi (Bacilli) Bacilli Gram+ Anaerobi (Clostridi) Cocchi Gram-:
UNIVERSITA' degli STUDI di PERUGIA Facoltà di MEDICINA e CHIRURGIA Corso di Laurea in Medicina e Chirurgia AA 2011-2012. Genere Staphylococcus
 UNIVERSITA' degli STUDI di PERUGIA Facoltà di MEDICINA e CHIRURGIA Corso di Laurea in Medicina e Chirurgia AA 2011-2012 Genere Staphylococcus I cocchi Gram positivi: 21 generi che colonizzano l uomo i
UNIVERSITA' degli STUDI di PERUGIA Facoltà di MEDICINA e CHIRURGIA Corso di Laurea in Medicina e Chirurgia AA 2011-2012 Genere Staphylococcus I cocchi Gram positivi: 21 generi che colonizzano l uomo i
COCCHI GRAM : - Morfologia delle colonie - Emolisi su agar sangue - Disposizione al Gram 2 FAMIGLIE TEST DELLA CATALASI :
 Staphylococcus COCCHI GRAM : - piccole, a goccia di rugiada - a cratere Streptococcaceae - Morfologia delle colonie - Emolisi su agar sangue - Disposizione al Gram 2 FAMIGLIE - rialzate, opache, cremose
Staphylococcus COCCHI GRAM : - piccole, a goccia di rugiada - a cratere Streptococcaceae - Morfologia delle colonie - Emolisi su agar sangue - Disposizione al Gram 2 FAMIGLIE - rialzate, opache, cremose
individuazione della causa di una patologia Diagnostica di laboratorio
 DIAGNOSI (διαγνωσισ = distinguere) individuazione della causa di una patologia Diagnosi su base clinica e/o anatomo-patologica sospetto o orientamento diagnostico Diagnosi di laboratorio (diagnosi eziologica)
DIAGNOSI (διαγνωσισ = distinguere) individuazione della causa di una patologia Diagnosi su base clinica e/o anatomo-patologica sospetto o orientamento diagnostico Diagnosi di laboratorio (diagnosi eziologica)
Esotossina: definizione Prodotto del metabolismo di alcuni batteri che viene riversato nel mezzo in cui essi sono posti a sviluppare Glicoproteine ad
 Esotossine ed Endotossine prof. Vincenzo Cuteri Esotossina: definizione Prodotto del metabolismo di alcuni batteri che viene riversato nel mezzo in cui essi sono posti a sviluppare Glicoproteine ad attività
Esotossine ed Endotossine prof. Vincenzo Cuteri Esotossina: definizione Prodotto del metabolismo di alcuni batteri che viene riversato nel mezzo in cui essi sono posti a sviluppare Glicoproteine ad attività
Cocchi gram positivi Staphylococcus e microorganismi correlati
 Cocchi gram positivi Staphylococcus e microorganismi correlati I cocchi gram positivi sono un gruppo eterogeneo di batteri con circa 16 specie patogene per l uomo Staphylococcus spp (dal greco staphylè:
Cocchi gram positivi Staphylococcus e microorganismi correlati I cocchi gram positivi sono un gruppo eterogeneo di batteri con circa 16 specie patogene per l uomo Staphylococcus spp (dal greco staphylè:
Farmaci utilizzati nelle malattie infettive
 Farmaci utilizzati nelle malattie infettive Concetti generali β-lattamine Ott 2002 Concetti generali Antibiosi, antibiotici Effetto batteriostatico / battericida Spettro d azione Resistenza Rapporto sito
Farmaci utilizzati nelle malattie infettive Concetti generali β-lattamine Ott 2002 Concetti generali Antibiosi, antibiotici Effetto batteriostatico / battericida Spettro d azione Resistenza Rapporto sito
I Batteri di interesse medico: criteri fondamentali per lo studio
 I Batteri di interesse medico: criteri fondamentali per lo studio Inquadramento dei batteri in un contesto generale Comprensione delle caratteristiche morfofunzionali (conoscenza del meccanismo dell azione
I Batteri di interesse medico: criteri fondamentali per lo studio Inquadramento dei batteri in un contesto generale Comprensione delle caratteristiche morfofunzionali (conoscenza del meccanismo dell azione
Staphylococcus aureus Concetta Scalfaro Istituto Superiore di Sanità
Staphylococcus aureus Concetta Scalfaro Istituto Superiore di Sanità Dipartimento di Sanità Pubblica Veterinaria e Sicurezza Alimentare Reparto Microrganismi e Tecnologie Alimentari Università di Tor Vergata,
Staphylococcus aureus Concetta Scalfaro Istituto Superiore di Sanità Dipartimento di Sanità Pubblica Veterinaria e Sicurezza Alimentare Reparto Microrganismi e Tecnologie Alimentari Università di Tor Vergata,
Haemophilus spp. Crescono su agar cioccolato e non su agar-sangue perché necessitano di: Fattore X (gruppo eme) e/o Fattore V (NAD)
 Crescono su agar cioccolato e non su agar-sangue perché necessitano di: Fattore X (gruppo eme) e/o Fattore V (NAD) Haemophilus spp coccobacilli Gram negativi pleomorfi diametro di 0.2-2.0 micron asporigeni
Crescono su agar cioccolato e non su agar-sangue perché necessitano di: Fattore X (gruppo eme) e/o Fattore V (NAD) Haemophilus spp coccobacilli Gram negativi pleomorfi diametro di 0.2-2.0 micron asporigeni
I principali mediatori chimici dell infiammazione
 I principali mediatori chimici dell infiammazione Mediatori plasmatici Danno endoteliale! Il Fattore di Hageman ha un ruolo centrale nell attivazione dei mediatori plasmatici Mediatori plasmatici: IL SISTEMA
I principali mediatori chimici dell infiammazione Mediatori plasmatici Danno endoteliale! Il Fattore di Hageman ha un ruolo centrale nell attivazione dei mediatori plasmatici Mediatori plasmatici: IL SISTEMA
MRSA QUIZ. LA 9 GIORNATA DI FORMAZIONE IN TICINO Britt Vallini
 Schweizerische Gesellschaft für Sterilgutversorgung Société de Stérilisation Hospitalière Società Svizzera di Sterilizzazione Ospedaliera MRSA QUIZ LA 9 GIORNATA DI FORMAZIONE IN TICINO Britt Vallini Domanda
Schweizerische Gesellschaft für Sterilgutversorgung Société de Stérilisation Hospitalière Società Svizzera di Sterilizzazione Ospedaliera MRSA QUIZ LA 9 GIORNATA DI FORMAZIONE IN TICINO Britt Vallini Domanda
Listeria monocytogenes
 Listeria monocytogenes Coccobacilli Gram+ Asporigeno Aerobio, Anaerobio facoltativo Comprende 6 specie, di cui solo 2 sono patogene per l uomo la monocytogenes e la L.ivanovi. Diametro di 0,4-0,5-2 micron
Listeria monocytogenes Coccobacilli Gram+ Asporigeno Aerobio, Anaerobio facoltativo Comprende 6 specie, di cui solo 2 sono patogene per l uomo la monocytogenes e la L.ivanovi. Diametro di 0,4-0,5-2 micron
Epidemiologia isolamenti batteri e miceti e sorveglianza antibiotico-resistenze. III trimestre Azienda Ospedaliera S.
 Epidemiologia isolamenti batteri e miceti e sorveglianza antibiotico-resistenze III trimestre 2012 Azienda Ospedaliera S.Orsola-Malpighi AREA PEDIATRICA Dott. Simone Ambretti U.O.Microbiologia [email protected]
Epidemiologia isolamenti batteri e miceti e sorveglianza antibiotico-resistenze III trimestre 2012 Azienda Ospedaliera S.Orsola-Malpighi AREA PEDIATRICA Dott. Simone Ambretti U.O.Microbiologia [email protected]
Epidemiologia isolamenti batteri e miceti e sorveglianza antibiotico-resistenze. II trimestre Azienda Ospedaliera S.
 Epidemiologia isolamenti batteri e miceti e sorveglianza antibiotico-resistenze II trimestre 2012 Azienda Ospedaliera S.Orsola-Malpighi AREA PEDIATRICA Dott. Simone Ambretti U.O.Microbiologia [email protected]
Epidemiologia isolamenti batteri e miceti e sorveglianza antibiotico-resistenze II trimestre 2012 Azienda Ospedaliera S.Orsola-Malpighi AREA PEDIATRICA Dott. Simone Ambretti U.O.Microbiologia [email protected]
Cocchi Gram+ anaerobi e bacilli non sporigeni
 Cocchi Gram+ anaerobi e bacilli non sporigeni Peptostreptococcus : Cocchi Gram+ colonizzano la cavità orale, il tratto GI, il tratto genitourinario e la cute. Essi causano malattia diffondendo da questi
Cocchi Gram+ anaerobi e bacilli non sporigeni Peptostreptococcus : Cocchi Gram+ colonizzano la cavità orale, il tratto GI, il tratto genitourinario e la cute. Essi causano malattia diffondendo da questi
Microbiologia: Classificazione e Morfologia. Coordinatore: Oliviero E. Varnier
 Microbiologia: Classificazione e Morfologia Coordinatore: Oliviero E. Varnier 010 353 7649 CLASSIFICAZIONE Classificazione Distribuzione dei microrganismi in gruppi tassonomici (taxa=categorie) basati
Microbiologia: Classificazione e Morfologia Coordinatore: Oliviero E. Varnier 010 353 7649 CLASSIFICAZIONE Classificazione Distribuzione dei microrganismi in gruppi tassonomici (taxa=categorie) basati
Parete cellulare. Cellula batterica
 Parete cellulare Cellula batterica Disposizione dei Cocchi Diplococchi Streptococchi Stafilococchi La cellula batterica STRUTTURE FONDAMENTALI MEMBRANA PARETE STRUTTURE ACCESSORIE CAPSULA Fimbrie/pili
Parete cellulare Cellula batterica Disposizione dei Cocchi Diplococchi Streptococchi Stafilococchi La cellula batterica STRUTTURE FONDAMENTALI MEMBRANA PARETE STRUTTURE ACCESSORIE CAPSULA Fimbrie/pili
Bordetella pertussis
 Bordetella pertussis : Pertosse o tosse canina. Bordetella parapertussis : forme minori di pertosse Bordetella bronchiseptica: malattia respiratoria occasionale nell uomo. Bacilli Gram- Diametro di 0,2-0,5
Bordetella pertussis : Pertosse o tosse canina. Bordetella parapertussis : forme minori di pertosse Bordetella bronchiseptica: malattia respiratoria occasionale nell uomo. Bacilli Gram- Diametro di 0,2-0,5
Epidemiologia isolamenti batteri e miceti e sorveglianza antibiotico-resistenze. IV trimestre Azienda Ospedaliera S.
 Epidemiologia isolamenti batteri e miceti e sorveglianza antibiotico-resistenze IV trimestre 2011 Azienda Ospedaliera S.Orsola-Malpighi AREA PEDIATRICA Dott. Simone Ambretti U.O.Microbiologia [email protected]
Epidemiologia isolamenti batteri e miceti e sorveglianza antibiotico-resistenze IV trimestre 2011 Azienda Ospedaliera S.Orsola-Malpighi AREA PEDIATRICA Dott. Simone Ambretti U.O.Microbiologia [email protected]
Genere Yersinia. dolore addominale oro-fecale gastroenterite. Y.pseudotuberculosis PATOLOGIA TRASMISSIONE
 Genere Yersinia i SPECIE PATOLOGIA TRASMISSIONE Y.pestis Peste zoonotica Y.enterocolitica Y.pseudotuberculosis adeno-mesenterite dolore addominale oro-fecale gastroenterite febbre Genere Yersinia Contaminazione
Genere Yersinia i SPECIE PATOLOGIA TRASMISSIONE Y.pestis Peste zoonotica Y.enterocolitica Y.pseudotuberculosis adeno-mesenterite dolore addominale oro-fecale gastroenterite febbre Genere Yersinia Contaminazione
Germi multiresistenti Profilo microbiologico
 Germi multiresistenti Profilo microbiologico Valeria Gaia Servizio di microbiologia EOLAB Bellinzona Gli antibiotici Farmaci antibatterici - Battericidi (uccidono) - Batteriostatici (impediscono la crescita)
Germi multiresistenti Profilo microbiologico Valeria Gaia Servizio di microbiologia EOLAB Bellinzona Gli antibiotici Farmaci antibatterici - Battericidi (uccidono) - Batteriostatici (impediscono la crescita)
Dati microbiologici I semestre Azienda Ospedaliera S.Orsola-Malpighi AREA CRITICA
 Dati microbiologici I semestre 2013 Azienda Ospedaliera S.Orsola-Malpighi AREA CRITICA Dott. Simone Ambretti U.O.Microbiologia [email protected] Come interpretare i dati 2 TIPI DI TABELLE 1. TABELLA
Dati microbiologici I semestre 2013 Azienda Ospedaliera S.Orsola-Malpighi AREA CRITICA Dott. Simone Ambretti U.O.Microbiologia [email protected] Come interpretare i dati 2 TIPI DI TABELLE 1. TABELLA
Argomenti trattati BATTERIOLOGIA SPECIALE. Genere Staphylococcus. Cocchi Gram-positivi di importanza medica
 Argomenti trattati 1. Introduzione - Batteriologia generale 2. Virologia generale e replicazione. 3. Micologia generale; alcuni patogeni d interesse clinico 4. Rapporto ospite-parassita, antibiotici, antivirali,
Argomenti trattati 1. Introduzione - Batteriologia generale 2. Virologia generale e replicazione. 3. Micologia generale; alcuni patogeni d interesse clinico 4. Rapporto ospite-parassita, antibiotici, antivirali,
Materiale del sito http://www.lezionidimedicina.altervista.org/ ARTRITI INFETTIVE
 ARTRITI INFETTIVE PATOGENESI L artrite settica può insorgere per diverse vie: 1. per via ematica = nell eroinomane, nel paziente con catetere a permanenza o con endocardite 2. per inoculazione diretta
ARTRITI INFETTIVE PATOGENESI L artrite settica può insorgere per diverse vie: 1. per via ematica = nell eroinomane, nel paziente con catetere a permanenza o con endocardite 2. per inoculazione diretta
Epidemiologia isolamenti batteri e miceti e sorveglianza antibiotico-resistenze. II trimestre Azienda Ospedaliera S.Orsola-Malpighi AREA CRITICA
 Epidemiologia isolamenti batteri e miceti e sorveglianza antibiotico-resistenze II trimestre 2012 Azienda Ospedaliera S.Orsola-Malpighi AREA CRITICA Dott. Simone Ambretti U.O.Microbiologia [email protected]
Epidemiologia isolamenti batteri e miceti e sorveglianza antibiotico-resistenze II trimestre 2012 Azienda Ospedaliera S.Orsola-Malpighi AREA CRITICA Dott. Simone Ambretti U.O.Microbiologia [email protected]
PERITONITI PERITONITI 28/12/2014. Peritoniti. Il peritoneo viscerale invece è innervato dal sistema nervoso autonomo.
 Dipartimento di Scienze Chirurgiche UOC di Chirurgia Generale N Corso di Laurea Infermieristica H Peritoniti Roberto Caronna [email protected] www.docvadis.it/roberto-caronna Peritoniti Occlusioni
Dipartimento di Scienze Chirurgiche UOC di Chirurgia Generale N Corso di Laurea Infermieristica H Peritoniti Roberto Caronna [email protected] www.docvadis.it/roberto-caronna Peritoniti Occlusioni
Microbiologia delle infezioni e sepsi correlate a catetere
 In collaborazione con Settore igiene ospedaliera e Centro studi EBN SEMINARIO Gestione dei cateteri venosi centrali 22 gennaio 2009 Policlinico Sant'Orsola-Malpighi Aula Murri Microbiologia delle infezioni
In collaborazione con Settore igiene ospedaliera e Centro studi EBN SEMINARIO Gestione dei cateteri venosi centrali 22 gennaio 2009 Policlinico Sant'Orsola-Malpighi Aula Murri Microbiologia delle infezioni
 Microbiologia parte speciale www.fisiokinesiterapia.biz Fonti: Michele la Placa: principi di Microbiologia Medica X edizione Società editrice Esculapio http://www.cdc.gov/; http://medic.med.uth.tmc.edu/path/catalase.htm;
Microbiologia parte speciale www.fisiokinesiterapia.biz Fonti: Michele la Placa: principi di Microbiologia Medica X edizione Società editrice Esculapio http://www.cdc.gov/; http://medic.med.uth.tmc.edu/path/catalase.htm;
Malattie trasmesse da alimenti contaminati. Sicurezza Alimentare
 Malattie trasmesse da alimenti contaminati Sicurezza Alimentare Spore batteriche In condizioni ambientali sfavorevoli alcuni batteri (sporigeni) danno origine a speciali forme di resistenza (spore). Quando
Malattie trasmesse da alimenti contaminati Sicurezza Alimentare Spore batteriche In condizioni ambientali sfavorevoli alcuni batteri (sporigeni) danno origine a speciali forme di resistenza (spore). Quando
Proprietà Esotossine Endotossine
 Principali differenze tra Esotossine ed Endotossine Proprietà Esotossine Endotossine Proprietà chimiche Modalità d azione Immunogenicità Potenzialità del tossoide Proteine secrete nell ambiente extracellulare
Principali differenze tra Esotossine ed Endotossine Proprietà Esotossine Endotossine Proprietà chimiche Modalità d azione Immunogenicità Potenzialità del tossoide Proteine secrete nell ambiente extracellulare
LA CLAMIDIOSI AVIARE
 LA CLAMIDIOSI AVIARE Infezione dei volatili sostenuta da Chlamydophila psittaci Batteri parassiti endocellulari Sensibili agli antibiotici Psittacosi Infezione da C. psittaci nei volatili psittacidi e
LA CLAMIDIOSI AVIARE Infezione dei volatili sostenuta da Chlamydophila psittaci Batteri parassiti endocellulari Sensibili agli antibiotici Psittacosi Infezione da C. psittaci nei volatili psittacidi e
Agenti antibatterici e Meccanismi resistenza
 Agenti antibatterici e Meccanismi resistenza I farmaci antibatterici sono attivi per la loro TOSSICITÀ SELETTIVA = capacità di uccidere/danneggiare i batteri senza danno per le cellule dell ospite. Terminologia
Agenti antibatterici e Meccanismi resistenza I farmaci antibatterici sono attivi per la loro TOSSICITÀ SELETTIVA = capacità di uccidere/danneggiare i batteri senza danno per le cellule dell ospite. Terminologia
COME FUNZIONA IL SISTEMA IMMUNITARIO
 COME FUNZIONA IL COME FUNZIONA IL SISTEMA IMMUNITARIO I vertebrati possiedono complessi meccanismi difensivi che costituiscono il sistema immunitario, che li protegge dall invasione di microrganismi patogeni,
COME FUNZIONA IL COME FUNZIONA IL SISTEMA IMMUNITARIO I vertebrati possiedono complessi meccanismi difensivi che costituiscono il sistema immunitario, che li protegge dall invasione di microrganismi patogeni,
Dati microbiologici I semestre Azienda Ospedaliera S.Orsola-Malpighi
 Dati microbiologici I semestre 2016 Azienda Ospedaliera S.Orsola-Malpighi AREA CRITICA Dott. Simone Ambretti U.O.Microbiologia [email protected] Come interpretare i dati TIPI DI TABELLE 1. TABELLA
Dati microbiologici I semestre 2016 Azienda Ospedaliera S.Orsola-Malpighi AREA CRITICA Dott. Simone Ambretti U.O.Microbiologia [email protected] Come interpretare i dati TIPI DI TABELLE 1. TABELLA
Dati microbiologici I semestre Azienda Ospedaliera S.Orsola-Malpighi
 Dati microbiologici I semestre 2016 Azienda Ospedaliera S.Orsola-Malpighi AREA CHIRURGICA Dott. Simone Ambretti U.O.Microbiologia [email protected] Come interpretare i dati TIPI DI TABELLE 1.
Dati microbiologici I semestre 2016 Azienda Ospedaliera S.Orsola-Malpighi AREA CHIRURGICA Dott. Simone Ambretti U.O.Microbiologia [email protected] Come interpretare i dati TIPI DI TABELLE 1.
Dati microbiologici I semestre Azienda Ospedaliera S.Orsola-Malpighi AREA PEDIATRICA
 Dati microbiologici I semestre 2015 Azienda Ospedaliera S.Orsola-Malpighi AREA PEDIATRICA Dott. Simone Ambretti U.O.Microbiologia [email protected] Come interpretare i dati 2 TIPI DI TABELLE 1.
Dati microbiologici I semestre 2015 Azienda Ospedaliera S.Orsola-Malpighi AREA PEDIATRICA Dott. Simone Ambretti U.O.Microbiologia [email protected] Come interpretare i dati 2 TIPI DI TABELLE 1.
Epidemiologia isolamenti batteri e miceti e sorveglianza antibiotico-resistenze. I trimestre Azienda Ospedaliera S.
 Epidemiologia isolamenti batteri e miceti e sorveglianza antibiotico-resistenze I trimestre 2012 Azienda Ospedaliera S.Orsola-Malpighi AREA INTERNISTICA Dott. Simone Ambretti U.O.Microbiologia [email protected]
Epidemiologia isolamenti batteri e miceti e sorveglianza antibiotico-resistenze I trimestre 2012 Azienda Ospedaliera S.Orsola-Malpighi AREA INTERNISTICA Dott. Simone Ambretti U.O.Microbiologia [email protected]
Il CAMPIONE BIOLOGICO
 LE INFEZIONI DEL TORRENTE CIRCOLATORIO Montebelluna, 28 Ottobre 2014 La Fase Preanalitica come Garanzia di Qualità Dr.ssa Stefania Schiavon Responsabile Preanalitica -Laboratorio di Analisi Il CAMPIONE
LE INFEZIONI DEL TORRENTE CIRCOLATORIO Montebelluna, 28 Ottobre 2014 La Fase Preanalitica come Garanzia di Qualità Dr.ssa Stefania Schiavon Responsabile Preanalitica -Laboratorio di Analisi Il CAMPIONE
Procedura per la prevenzione delle Infezioni da microrganismi farmaco resistenti (Multi-Drug-Resistant Organisms)
 Procedura per la prevenzione delle Infezioni da microrganismi farmaco resistenti (Multi-Drug-Resistant Organisms) 2016 2 Premessa Dal punto di vista epidemiologico, si definiscono microrganismi multifarmaco-resistenti
Procedura per la prevenzione delle Infezioni da microrganismi farmaco resistenti (Multi-Drug-Resistant Organisms) 2016 2 Premessa Dal punto di vista epidemiologico, si definiscono microrganismi multifarmaco-resistenti
Piccole proteine (15-30kDal) Riconosciute da recettori Secrete da diversi tipi cellulari
 Piccole proteine (15-30kDal) Riconosciute da recettori Secrete da diversi tipi cellulari La gran parte delle citochine sono per convenzione chiamate interleuchine ad indicare che queste sono prodotte dai
Piccole proteine (15-30kDal) Riconosciute da recettori Secrete da diversi tipi cellulari La gran parte delle citochine sono per convenzione chiamate interleuchine ad indicare che queste sono prodotte dai
INTRODUZIONE ALLE REAZIONI FLOGISTICHE
 INTRODUZIONE ALLE REAZIONI FLOGISTICHE INCONTRO FRA CELLUA E NOXA PATOGENA: SEQUENZA DEGLI EVENTI noxa patogena adattamento cellula danno irreversibile danno reversibile - stress proteins - enzimi di riparazione
INTRODUZIONE ALLE REAZIONI FLOGISTICHE INCONTRO FRA CELLUA E NOXA PATOGENA: SEQUENZA DEGLI EVENTI noxa patogena adattamento cellula danno irreversibile danno reversibile - stress proteins - enzimi di riparazione
Struttura degli anticorpi
 Struttura degli anticorpi (220 aa) (440 aa) Le classi di anticorpi Ig A, IgD, IgE, IgG, IgM IgM Risposta primaria Attivazione della fagocitosi attivazione del complemento IgM monomeriche insieme alle IgD
Struttura degli anticorpi (220 aa) (440 aa) Le classi di anticorpi Ig A, IgD, IgE, IgG, IgM IgM Risposta primaria Attivazione della fagocitosi attivazione del complemento IgM monomeriche insieme alle IgD
1 a prova TAMPONE FARINGEO. - Faringite in pz di 30 anni - Streptococchi beta emolitici A, C, G. Ricerca di. Esame microscopico diretto
 PROVA PRATICA 1 a prova TAMPONE FARINGEO - Faringite in pz di 30 anni - Ricerca di Streptococchi beta emolitici A, C, G Esame microscopico diretto NO Esame colturale Terreni di coltura SI Agar sangue CNA
PROVA PRATICA 1 a prova TAMPONE FARINGEO - Faringite in pz di 30 anni - Ricerca di Streptococchi beta emolitici A, C, G Esame microscopico diretto NO Esame colturale Terreni di coltura SI Agar sangue CNA
STREPTOCOCCHI. Insieme agli Stafilococchi costituiscono il gruppo più importante di cocchi Gram+ dal punto di vista clinico.
 STREPTOCOCCHI Gram + Cocchi (1 micron) Disposti a catenella Immobili Capsulati Aerobi-anaerobi facoltativi Catalasi negativi (Stafilococchi catalasi +) Ossidasi negativi Asporigeni Esigenti: crescono su
STREPTOCOCCHI Gram + Cocchi (1 micron) Disposti a catenella Immobili Capsulati Aerobi-anaerobi facoltativi Catalasi negativi (Stafilococchi catalasi +) Ossidasi negativi Asporigeni Esigenti: crescono su
Antibiotici e antibiotico-resistenza
 Antibiotici e antibiotico-resistenza Alexander Fleming La piastra originale La muffa: Penicillium notatum Colonie di S.aureus CHEMIOTERAPIA ANTIMICROBICA ANTIBIOTICI : definizioni Con il termine antibiotico
Antibiotici e antibiotico-resistenza Alexander Fleming La piastra originale La muffa: Penicillium notatum Colonie di S.aureus CHEMIOTERAPIA ANTIMICROBICA ANTIBIOTICI : definizioni Con il termine antibiotico
Caratteristiche generali della reazione infiammatoria
 Caratteristiche generali della reazione infiammatoria Localizzazione tessuti interstiziali cavità interne del corpo: cavo pleurico, cavo peritoneale, cavo pericardico, vaginale del testicolo, cavità articolari
Caratteristiche generali della reazione infiammatoria Localizzazione tessuti interstiziali cavità interne del corpo: cavo pleurico, cavo peritoneale, cavo pericardico, vaginale del testicolo, cavità articolari
SISTEMATICA DEI MICRO-STAFILOCOCCHI
 MICRO-STAFILOCOCCHI SISTEMATICA DEI MICRO-STAFILOCOCCHI APPARTENGONO ALLA FAMIGLIA DELLE STAPHYLOCOCCACEAE E DELLE MICROCOCCACEAE A CUI SONO ASCRITTI GENERI CON CELLULE DI FORMA COCCICA, GRAM+ E CATALASI
MICRO-STAFILOCOCCHI SISTEMATICA DEI MICRO-STAFILOCOCCHI APPARTENGONO ALLA FAMIGLIA DELLE STAPHYLOCOCCACEAE E DELLE MICROCOCCACEAE A CUI SONO ASCRITTI GENERI CON CELLULE DI FORMA COCCICA, GRAM+ E CATALASI
Dati microbiologici I semestre Azienda Ospedaliera S.Orsola-Malpighi AREA INTERNISTICA
 Dati microbiologici I semestre 2015 Azienda Ospedaliera S.Orsola-Malpighi AREA INTERNISTICA Dott. Simone Ambretti U.O.Microbiologia [email protected] Come interpretare i dati TIPI DI TABELLE 1.
Dati microbiologici I semestre 2015 Azienda Ospedaliera S.Orsola-Malpighi AREA INTERNISTICA Dott. Simone Ambretti U.O.Microbiologia [email protected] Come interpretare i dati TIPI DI TABELLE 1.
Infezioni ospedaliere (IO)
 Infezioni ospedaliere (IO) Infezioni che non erano clinicamente manifeste né in incubazione al momento del ricovero. Le infezioni ospedaliere possono manifestarsi anche dopo la dimissione o essere presenti
Infezioni ospedaliere (IO) Infezioni che non erano clinicamente manifeste né in incubazione al momento del ricovero. Le infezioni ospedaliere possono manifestarsi anche dopo la dimissione o essere presenti
4ª UNITA DIDATTICA Modello Nutrizionale metabolico
 4ª UNITA DIDATTICA Modello Nutrizionale metabolico Contenuti Modello Nutrizionale metabolico Sezione del modello: Equilibrio idro-elettrolitico e acido-base Assistenza alla persona con problemi relativi
4ª UNITA DIDATTICA Modello Nutrizionale metabolico Contenuti Modello Nutrizionale metabolico Sezione del modello: Equilibrio idro-elettrolitico e acido-base Assistenza alla persona con problemi relativi
Borrelia. Agenti eziologici della: Febbre ricorrente epidemica (pidocchio) Febbre ricorrente endemica (zecca) Malattia di Lyme (zecche)
 Borrelia Agenti eziologici della: Febbre ricorrente epidemica (pidocchio) Febbre ricorrente endemica (zecca) Malattia di Lyme (zecche) Borrelia Bacilli Gram negativi Diametro di 0.2-0.5 x 3-30 micron Si
Borrelia Agenti eziologici della: Febbre ricorrente epidemica (pidocchio) Febbre ricorrente endemica (zecca) Malattia di Lyme (zecche) Borrelia Bacilli Gram negativi Diametro di 0.2-0.5 x 3-30 micron Si
CORSO INTEGRATO DI IMMUNOLOGIA ED IMMUNOPATOLOGIA. Prof. Roberto Testi Indirizzo
 CORSO INTEGRATO DI IMMUNOLOGIA ED IMMUNOPATOLOGIA COORDINATORE Prof. Roberto Testi Indirizzo e-mail: [email protected] SVOLGIMENTO DEL CORSO: I parte. Immunologia II parte. Immunopatologia 1 LIBRI
CORSO INTEGRATO DI IMMUNOLOGIA ED IMMUNOPATOLOGIA COORDINATORE Prof. Roberto Testi Indirizzo e-mail: [email protected] SVOLGIMENTO DEL CORSO: I parte. Immunologia II parte. Immunopatologia 1 LIBRI
Patogenicità Capacità di un microrganismo di causare malattia infettiva. Infezione. Malattia infettiva
 Capacità offensive microrganismo Infezione? Malattia infettiva Capacità difensive ospite Patogenicità Capacità di un microrganismo di causare malattia infettiva Patogeni veri : es agenti della peste agenti
Capacità offensive microrganismo Infezione? Malattia infettiva Capacità difensive ospite Patogenicità Capacità di un microrganismo di causare malattia infettiva Patogeni veri : es agenti della peste agenti
ALLU MARIA TERESA U.O.C. PATOLOGIA CLINICA 2 OTTOBRE
 ALLU MARIA TERESA U.O.C. PATOLOGIA CLINICA 2 OTTOBRE DIAGNOSI DI SEPSI: EMOCOLTURA rileva microrganismi vitali (batteri o funghi) coltivabili in vitro 1897 - Liebman descrive due casi di batteriemia 1906
ALLU MARIA TERESA U.O.C. PATOLOGIA CLINICA 2 OTTOBRE DIAGNOSI DI SEPSI: EMOCOLTURA rileva microrganismi vitali (batteri o funghi) coltivabili in vitro 1897 - Liebman descrive due casi di batteriemia 1906
Il mondo microbico Introduzione agli agenti infettivi La Microbiologia e le sue suddivisioni
 Indice PARTE I MICROBIOLOGIA GENERALE E SPECIALE Capitolo 1 Il mondo microbico 3 1.1 Introduzione agli agenti infettivi 1.1.1 La Microbiologia e le sue suddivisioni 5 1.2 Aspetti generali e classificazione
Indice PARTE I MICROBIOLOGIA GENERALE E SPECIALE Capitolo 1 Il mondo microbico 3 1.1 Introduzione agli agenti infettivi 1.1.1 La Microbiologia e le sue suddivisioni 5 1.2 Aspetti generali e classificazione
I CARDINI DELLA TERAPIA ANTIBIOTICA
 I CARDINI DELLA TERAPIA ANTIBIOTICA Quali sono le regole fondamentali che tutti i medici dovrebbero sapere sugli antibiotici? Il limite della maggior parte dei testi di antibioticoterapia è quello di perdersi
I CARDINI DELLA TERAPIA ANTIBIOTICA Quali sono le regole fondamentali che tutti i medici dovrebbero sapere sugli antibiotici? Il limite della maggior parte dei testi di antibioticoterapia è quello di perdersi
C.d.L. Scienze Biosanitarie e Farmaceutiche Corso di Microbiologia e Biotecnologie dei Microrganismi
 C.d.L. Scienze Biosanitarie e Farmaceutiche Corso di Microbiologia e Biotecnologie dei Microrganismi AA 2007 2008 ANTIBIOTICI 1 1 Penicillium notatum. Alexander Fleming 2 Antibiotici 3DEFINZI ONE DI ANTIBIO
C.d.L. Scienze Biosanitarie e Farmaceutiche Corso di Microbiologia e Biotecnologie dei Microrganismi AA 2007 2008 ANTIBIOTICI 1 1 Penicillium notatum. Alexander Fleming 2 Antibiotici 3DEFINZI ONE DI ANTIBIO
Controllo della crescita con antibiotici: batteriostatici
 La curva di crescita in terreno liquido: un modello di fisiologia batterica Controllo della crescita con antibiotici: batteriostatici Momento di aggiunta dell antibiotico Densità ottica Arresto della crescita
La curva di crescita in terreno liquido: un modello di fisiologia batterica Controllo della crescita con antibiotici: batteriostatici Momento di aggiunta dell antibiotico Densità ottica Arresto della crescita
Nuove linee di antibioticoterapia
 Nuove linee di antibioticoterapia Paolo Viganò Malattie infettive A.O. Legnano opportunità e rischi Desenzano, 13 maggio 2014 Prima di iniziare una terapia antibiotica Prima di iniziare una terapia antibiotica
Nuove linee di antibioticoterapia Paolo Viganò Malattie infettive A.O. Legnano opportunità e rischi Desenzano, 13 maggio 2014 Prima di iniziare una terapia antibiotica Prima di iniziare una terapia antibiotica
bronchite, enfisema, asma, bronchiectasie e proteinosi valvolare. infezioni cutanee, linfocutanee, ascessi superficiali, cellulite.
 Actinomiceti aerobi Bacilli Gram+,Catalasi + Possiedono acidi micolici Sono parzialmente acido-alcoli resistenti Formano ife ramificate nei tessuti ed in coltura L analisi filogenetica del DNA ribosomiale
Actinomiceti aerobi Bacilli Gram+,Catalasi + Possiedono acidi micolici Sono parzialmente acido-alcoli resistenti Formano ife ramificate nei tessuti ed in coltura L analisi filogenetica del DNA ribosomiale
MICOSI PROFONDE MICOSI PROFONDE CRITOTOCOCCOSI
 MICOSI PROFONDE Le micosi profonde sono infezioni che interessano solitamente il polmone, le quali possono eventualmente disseminare per via ematica con coinvolgimento degli organi interni e della cute
MICOSI PROFONDE Le micosi profonde sono infezioni che interessano solitamente il polmone, le quali possono eventualmente disseminare per via ematica con coinvolgimento degli organi interni e della cute
Dati microbiologici I semestre Azienda Ospedaliera S.Orsola-Malpighi AREA CRITICA
 Dati microbiologici I semestre 2015 Azienda Ospedaliera S.Orsola-Malpighi AREA CRITICA Dott. Simone Ambretti U.O.Microbiologia [email protected] Come interpretare i dati TIPI DI TABELLE 1. TABELLA
Dati microbiologici I semestre 2015 Azienda Ospedaliera S.Orsola-Malpighi AREA CRITICA Dott. Simone Ambretti U.O.Microbiologia [email protected] Come interpretare i dati TIPI DI TABELLE 1. TABELLA
Corso di Laurea in Infermieristica - II anno Università degli Studi di Perugia. Procedura per il. Prelievo Emocolture. Dr.
 Corso di Laurea in Infermieristica - II anno Università degli Studi di Perugia Procedura per il Prelievo Emocolture Dr.ssa Michela Sereni DEFINIZIONE L emocoltura rappresenta un esame di laboratorio fondamentale
Corso di Laurea in Infermieristica - II anno Università degli Studi di Perugia Procedura per il Prelievo Emocolture Dr.ssa Michela Sereni DEFINIZIONE L emocoltura rappresenta un esame di laboratorio fondamentale
Minicorso 9. Gestione integrata dell ulcera diabetica infetta. Terapia medica
 Minicorso 9 Gestione integrata dell ulcera diabetica infetta Terapia medica Paolo Falasca UOC Medicina Interna Ospedale San Sebastiano Martire Frascati Linee guida IDSA BA Lipsky et al. Clin Inf Diseases
Minicorso 9 Gestione integrata dell ulcera diabetica infetta Terapia medica Paolo Falasca UOC Medicina Interna Ospedale San Sebastiano Martire Frascati Linee guida IDSA BA Lipsky et al. Clin Inf Diseases
APPROCCIO OMEOPATICO NELLE IMMUNOREAZIONI ATOPICHE DI TIPO I
 APPROCCIO OMEOPATICO NELLE IMMUNOREAZIONI ATOPICHE DI TIPO I 1 DEFINIZIONE DI ALLERGIA REAZIONE ANOMALA DELL ORGANISMO, VERSO SOSTANZE ESTRANEE PERCHE? di solito, ma non sempre, la degranulazione avviene
APPROCCIO OMEOPATICO NELLE IMMUNOREAZIONI ATOPICHE DI TIPO I 1 DEFINIZIONE DI ALLERGIA REAZIONE ANOMALA DELL ORGANISMO, VERSO SOSTANZE ESTRANEE PERCHE? di solito, ma non sempre, la degranulazione avviene
Meccanismi effettori dei linfociti T citotossici
 Meccanismi effettori dei linfociti T citotossici Immunità specifica: caratteristiche generali Immunità umorale - Riconoscimento dell antigene mediante anticorpi - Rimozione patogeni e tossine extracellulari
Meccanismi effettori dei linfociti T citotossici Immunità specifica: caratteristiche generali Immunità umorale - Riconoscimento dell antigene mediante anticorpi - Rimozione patogeni e tossine extracellulari
LE MALATTIE ALIMENTARI di origine batterica. ERUCON - ERUditio et CONsultum
 LE MALATTIE ALIMENTARI di origine batterica INTOSSICAZIONI ALIMENTARI consumo di alimenti contenenti tossine prodotte da microrganismi che si sono moltiplicati nell alimento precedentemente al suo consumo
LE MALATTIE ALIMENTARI di origine batterica INTOSSICAZIONI ALIMENTARI consumo di alimenti contenenti tossine prodotte da microrganismi che si sono moltiplicati nell alimento precedentemente al suo consumo
Infiammazione (flogosi)
 Infiammazione (flogosi) Reazione di un tessuto vascolarizzato ad un danno locale Componente vascolare Componente cellulare Infiammazione acuta Calor Rubor Tumor Dolor Functio laesa Equilibrio dei fluidi
Infiammazione (flogosi) Reazione di un tessuto vascolarizzato ad un danno locale Componente vascolare Componente cellulare Infiammazione acuta Calor Rubor Tumor Dolor Functio laesa Equilibrio dei fluidi
